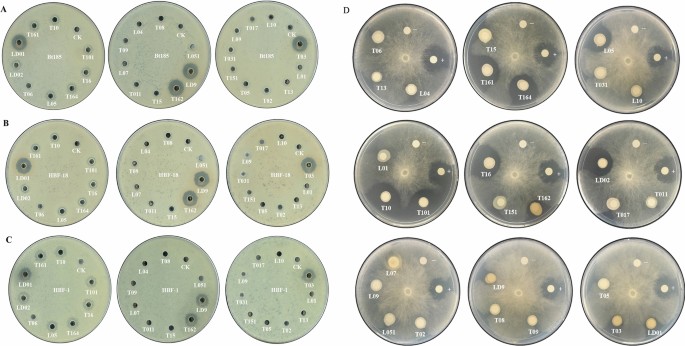
figure 5

Abstract
Holotrichia oblita (Coleoptera: Scarabaeidae) and some other scarab beetles are the main soil-dwelling pests in China. Bacillus thuringiensis (Bt) and Beauveria bassiana (Bb) are entomopathogens that have been used as biocontrol agents of various pests. However, scarab larvae especially H. oblita exhibited strong adaptability to these pathogens. Compared to other scarabs, H. oblita could form a specific soil egg case (SEC) structure surrounding its eggs, and young larvae complete the initial development process inside this structure. In this study, we investigated the role of SEC structure and microorganisms from SEC and egg surface in pathogen adaptability. 16S rRNA gene analysis revealed low bacterial richness and high community unevenness in egg surface, with Proteobacteria, Firmicutes, Bacteroidetes and Fusobacteria dominating. In terms of OTUs composition analysis, the data show that the egg surface contains a large number of unique bacteria, indicating that the egg bacterial community may be derived from maternal transmission. Furthermore, we found that all culturable bacteria isolated from egg surface possessed antimicrobial activity against both Bt and Bb. The Pseudomonas bacteria with a significantly higher abundance in egg surface showed strong Bt- and Bb antagonistic ability. In conclusion, this study demonstrated a unique and antimicrobial bacterial community of H. oblita egg surface, which may contribute to its adaptability. Furthermore, the specific SEC structure surrounding the H. oblita eggs will provide a stable microenvironment for the eggs and egg surface bacteria, which probably provides more advantages for H. oblita adaptation ability.
Similar content being viewed by others
Introduction
Holotrichia oblita (Coleoptera: Scarabaeidae) and some other scarab beetles are the main soil-dwelling pests in China, which cause significant economic losses in agriculture, horticulture, and forestry. The larvae living in soil, known as white grubs, feed on the underground parts of most crops in the field such as sweet potatoes, soybeans, peanuts. And adults damage the leaves of trees and field crops1. Chemical pesticides are often used to control grubs, but the extensive use of chemicals leads to serious soil pollution and poses a threat to the human and ecological health2. Soil not only supports plant and animal life, but also hosts myriad microorganisms inside, including many entomopathogenic microorganisms, some of which have been isolated and applied as biocontrol agents, such as Beauveria bassiana (Bb) and Bacillus thuringiensis (Bt)3. To date, many Bt and Bb isolates have been reported to have activity against scarab beetles4,5,6,7.
In the past ten years, our institute has done a lot of works on biological properties and efficient control strategies of these scarab pests, and previous data indicate that scarab larvae exhibit strong adaptability to pathogens6,7. The field grub population always causes significant losses, although there are a plenty of entomopathogenic microbes in soil. And when applying Bt and Bb agents in the field, the scarab pests especially H. oblita usually need more dosage than leaf-feeding Lepidoptera pests6,7,8,9.
Bb and Bt have different modes of action. The Bb species attack their host insects generally percutaneously, which can directly penetrate through the insect cuticle by germination of the spores and proliferation within the host by formation of hyphal bodies/blastospores10. Different from Bb, Bt functions as a stomach insecticide. The main Bt virulence factors are the parasporal crystals proteins (Cry) produced during sporulation11. In addition, Bt can produce other virulence factors during vegetative growth stage, such as vegetative insecticidal proteins (Vip), bacteriocins, chitinases and enhancins8,12. Therefore, Bt cell also contributes to its insecticidal activity. Garbutt et al. also confirmed that Bt cell with stronger proliferation ability in the insect body would significantly enhance the insecticidal activity13. Additionally, Bt cell can proliferate in the rhizosphere of plants where the scarabs lay their eggs, which means that more insecticidal proteins and virulence factors are produced and exposed to the eggs and larvae14. Therefore, we hypothesize that the scarab adaptability against pathogens might be correlated with their ability of inhibiting the multiplication of Bt and Bb.
Young larval stages are more sensitive to the pathogen7,15. Under natural conditions, scarab adults usually lay their eggs in the soil near their preferred host plants, where the newly hatched larvae are exposed to the rich soil microflora including these entomopathogenic microorganisms. Therefore, we investigate the biological features of scarab eggs and larvae. And we find that H. oblita egg is coated with a unique soil egg case (SEC) structure, which is different from two other scarab pests H. parallela and Anomala corpulenta (see Fig. 1). Previous data indicated that invertebrate eggs were usually defensed by the protective systems provided by maternal organisms. For example, tick eggs were protected by the antimicrobial factors on the egg surface16,17; spider eggs were protected well by the silk cocoon provided by the female spiders18. Therefore, in this work, to understand the role of SEC structure and egg bacteria in pathogen adaptability, we analyzed the microbial community structure of H. oblita egg surface and SEC structure respectively using 16S rRNA gene sequencing; furthermore, we tested the antimicrobial potential of the cultivable isolates from egg surface and SEC against scarab-specific Bt and Bb strains. The results suggest that egg surface has a unique bacterial and antimicrobial community, contributing to the low susceptibility of young larvae against entomopathogenic pathogens. And the specific SEC structure provides protection for the eggs and hatchlings of H. oblita, which is beneficial for better adaptation ability of H. oblita.
Results
Microbial diversity comparisons between egg and soil samples
The bacterial composition of different samples from H. oblita egg surface (E), SEC (C), and bulk soil (B) (Fig. 1) was determined by sequencing analysis of the 16S rRNA gene. A total of 2,748,824 raw reads were generated from 20 samples, including 667,427 raw reads from six E samples, 924,724 raw reads from seven C samples, and 1,156,673 raw reads from seven B samples. After removing the short reads and trimming the low-quality regions, a total of 1,894,784 effective tags were identified, with an average length of 415 bp (Table S1). All the effective sequences were grouped at 97% DNA sequence similarity, and an average of 3545, 3261 and 311 OTUs were obtained from bulk soil (B), soil egg case (C) and egg surface (E) samples, respectively (Table 1). A total of 5520 non-redundant OTUs were identified from bulk soil (4987 OUTs), SEC structure (4708 OTUs) and egg surface (824 OTUs), respectively (Fig. 2). Among the 824 OTUs identified in egg surface, 352 unique OTUs (42.72%) were not detected in both bulk soil and SEC structure.
Alpha diversity analysis was then performed to assess the diversity and evenness of the microbial population from different samples. The alpha diversity patterns were variable across the bulk soil (B), SEC (C) and egg surface (E) samples (Table 1). The number of observed OTUs and alpha diversity analysis based on Shannon and Chao1 indexes in egg surface (E) significantly decreased than SEC (C) and bulk soil (B), indicating that soil samples had more microbial diversity than the egg surface samples (Table 1). A previous study in our laboratory showed that the microorganism collection method could affect the community structure, where the phyllosphere community diversity was lower for samples subjected to DNA extraction than for those subjected to direct PCR19. In the present study, we performed direct PCR for egg surface (E) samples and added a DNA extraction process before PCR for SEC (C) and bulk soil (B) samples. The results confirmed that the community diversity of soil samples was much higher than the egg surface samples. The results of Simpson, Dominance and Equitability indexes indicated that, compared to SEC (C) and bulk soil (B) samples, the evenness of egg surface (E) decreased (Table 1). The rarefaction curve based on the Shannon index showed that all samples reached a plateau, suggesting that our sampling effort was sufficient to obtain a full estimate of OTU richness (Figure S1).
Among all samples, 26 phyla, 143 families, and 300 genera were identified. Proteobacteria was the dominant phylum and comprised most of all detected microorganisms (approximately 44.63%) (Fig. 3A). This is typically observed in other soil libraries20,21. Actinobacteria, Acidobacteria and Bacteroidetes were also abundant in SEC (C) samples and bulk soil (B) samples. In egg surface (E) samples, Firmicutes, Bacteroidetes, and Fusobacteria were the most abundant phyla (Fig. 3A). The community structure varied markedly among different samples, outlined by the Lefse LDA results (Fig. 3C). Compared with bulk soil (B) samples, the composition of Firmicutes, Bacteroidetes, Fusobacteria and the composition of Actinobacteria, Acidobacteria significantly increased in egg surface (E) samples and SEC (C) samples, respectively (Fig. 3C). Bray–Curtis tree and PCA analysis also indicated that microbiota in different samples were clearly separated at the phylum level (Fig. 3A,D). PC1 and PC2 explained 73.8% and 14.8% of the global variation, respectively (Fig. 3D). Similar results were observed in the NMDS analysis based on Weighted UniFrac distances (Figure S2).
Taxonomic composition of microbial communities in different samples (B: bulk soil, C: SEC and E: egg surface). (A) Relative abundance of the microbes at phylum level and (B) family level respectively. The sample variation in the community structure is also highlighted in the Bray–Curtis tree (A) and cluster tree (B). (C) Comparison of microbiota using Lefse (LDA) test at the phylum level. LDA scores represent the significant microbial difference among different samples. (D) PCA analysis for microbiota variability at the phylum level. Each symbol represents a sample. The variance explained by the PCs is indicated on the axes.
At the family level, Sphingomonadaceae and Xanthomonadaceae in phylum Proteobacteria and Chitinophagaceae in phylum Bacteroidetes were enriched in bulk soil (B) samples. Rhodospirillaceae in phylum Proteobacteria and Micrococcaceae in phylum Actinobacteria were enriched in SEC (C) samples. The families Enterobacteriaceae, Moraxellaceae, and Desulfovibrionaceae in phylum Proteobacteria, Porphyromonadaceae in phylum Bacteroidetes, Leptotrichiaceae in phylum Fusobacteria, Ruminococcaceae and Lachnospiraceae in phylum Firmicutes were enriched in egg surface (E) samples (Fig. 3B). Differences were also observed at the class, order and genus level (Figure S3).
From 20 samples, we isolated 28 strains with different colony morphology and found the number of cultivable isolates from bulk soil samples (18 strains from B) was much higher than SEC samples (7 strains from C) and egg surface samples (3 strains from E). Then we performed 16S rRNA gene sequencing to identify these 28 isolated strains. All the sequences were aligned against the NCBI database using BLAST, and the results showed that these 28 isolates belonged to two phyla, Proteobacteria and Firmicutes. Phylogenetic analysis based on the 16S rRNA sequences revealed that these 28 isolates clustered into four major groups at the family level, i.e., Alcaligenaceae, Pseudomonadaceae, Enterobacteriaceae, and Bacillaceae (Fig. 4). Alcaligenaceae, Enterobacteriaceae, and Pseudomonadaceae belonged to the Proteobacteria phylum, which constituted the largest group (23 isolates). The other five Bacillaceae strains belonged to the Firmicutes phylum (Table S2).
Phylogenetic analysis of 28 cultivable isolates. The tree is constructed based on the 16S rRNA gene sequences of each strain. Bootstrap values over 0.5 (1000 replications) are indicated using filled purple circles on the branch. Strain ID prefixed with “LD” indicates egg surface (E) isolates, strain ID prefixed with “L” indicates SEC (C) isolates, and strain ID prefixed with “T” indicates bulk soil (B) isolates. Different label background colors represent different clades at the family level. The antimicrobial activity against “Bt” or “Bb” strains is indicated using pentagram symbols, filled black pentagrams represent strong antimicrobial activity, partially filled pentagrams represent weak antimicrobial activity, and open pentagrams represent no antimicrobial activity.
The 18 isolates from bulk soil (B) samples were composed of 7 different genera, Alcaligenes, Citrobacter, Bacillus, Pseudomonas, Klebsiella, Enterobacter, and Serratia. The seven isolates from SEC (C) samples were composed of four genera, Alcaligenes, Bacillus, Citrobacter, and Klebsiella. The three isolates from egg surface (E) samples were composed of two genera, Alcaligenes and Pseudomonas (Table S2).
The effects of cultivable isolates against pathogens
We assessed the antimicrobial activity of the 28 cultivable isolates against scarab-specific Bt and Bb strains. The confrontation culture analysis showed that strains (LD01, LD9) from H. oblita egg surface (E) samples and strains (T03, T162) from bulk soil (B) samples had strong antagonistic ability against all three scarab-specific Bt strains and weak antagonistic ability against the Bb strain. All these four strains were Pseudomonas. Strain LD02 from E samples, strain L05 from C samples, and strains (T10, T16, T101, T161, T164) from B samples showed weak antagonistic ability against all three Bt strains but showed strong antagonistic ability against the Bb strain. These seven strains belonged to Alcaligenes. The remaining 17 strains showed no antagonistic ability against the Bt and Bb strains, including 12 Proteobacteria strains and 5 Firmicutes strains (Fig. 5 and Table S2).
Effect of 28 cultivable isolates against the scarab-specific Bt strain Bt185 (A), HBF-18 (B), HBF-1 (C), and Bb strain (D). CK in (A), (B), and (C) and symbol “−” in (D) signifies negative control. The symbol “+” in (D) signifies positive control. Strain ID prefixed with “LD” indicates egg surface isolates, strain ID prefixed with “L” indicates SEC isolates, and strain ID prefixed with “T” indicates bulk soil isolates.
All the three isolates from E samples showed antagonistic ability (100%, N = 3) against pathogens, where the proportions of antimicrobial isolates in B and C samples were 38.89% (N = 18) and 14.29% (N = 7), respectively.
Genome sequencing and secondary metabolite analysis of strains with antimicrobial activity
The four strains (LD01, LD9, T03, and T162) with strong Bt-antagonistic ability and weak Bb-antagonistic ability were genome sequenced using the Illumina platform. After assembly and gene predication, 5885, 5857, 5850 and 5859 protein-coding sequences (CDS) were identified from LD01, LD9, T03 and T162, respectively (Table S3). The 16S rRNA gene sequence identification showed that these four strains belonged to the genus Pseudomonas and had the highest similarity with P. aeruginosa strain DSM50071 (99.51–99.79%). Therefore, we collected 20 additional Pseudomonas strain genomes from the NCBI GeneBank database (http://www.ncbi.nlm.nih.gov/), including 11 P. aeruginosa strains, 7 P. mendocina strains, 1 P. denitrificans strain, and 1 P. reidholzensis strain (Fig. 6 and Table S4). The whole-genome-based phylogenetic tree was constructed using CVTree and PHYLIP, with Bt kurstaki strain HD73 as an outgroup. The CVTree is an alignment-free method where each organism is represented by a Composition Vector (CV) derived from all proteins present in its genome. CVTree has been effectively used in several phylogenetic studies of microorganisms including archaea, prokaryotes, and fungi22,23,24. The results showed that these four strains were clustered with P. aeruginosa strains, indicating they belonged to P. aeruginosa. The blue-green coloration produced during culture verified this result. Phylogenetic analysis also showed high genome similarity among these four P. aeruginosa strains, suggesting that they might be the same strain. As an opportunistic human pathogen, P. aeruginosa can be isolated from various sources, including humans, animals, hospitals, swimming pools, soil, rhizosphere, and plants25. P. aeruginosa is also a promising biocontrol agent for plant pathogens and pests such as Pythium sp. and the root-knot nematode (Meloidogyne incognita)26,27. Nga et al. found that P. aeruginosa isolated from the rhizosphere of a watermelon plant showed high antagonistic ability against both bacterial and fungal pathogens on rice, watermelon, and cabbage28. Our study showed that P. aeruginosa also had antagonistic ability against entomopathogenic Bt and Bb strains.
Then we used antiSMASH 2.0 pipeline to identify and annotate the putative secondary metabolite biosynthesis gene clusters in the four strains. A total of 62 gene clusters were identified, including 18 NRPS (non-ribosomal peptide synthetase cluster), 9 NRPS-like fragments, 8 hserlactone (homoserine lactone cluster), 7 bacteriocin, 8 phenazine, 4 CDPS (tRNA-dependent cyclodipeptide synthases), 4 NAGGN (N-acetyl-glutaminyl-glutamine-amide), and 4 thiopeptides (Table S5).
Discussion
In China, although scarab pests cause significant yield reductions and economic losses each year, but due to the difficulty of these insect rearing in laboratory conditions, researches on these scarab beetles are very limited. Our institute has been focused on the biological properties and efficient control strategies of scarab pests for many years, and previous data indicate that scarab larvae exhibit strong adaptability to pathogens. Smith’s work on fossil record has demonstrated that Scarabaeoidea is quite resilient to external environment. Scarab beetles belong to polyphagan, the group of which first appears in the Triassic and has a family-level extinction rate of zero for most of their evolutionary history29. These data suggest that the scarab insects have a strong environment adaptability, which can be a challenge to the control of this group pests.
The environment adaptability was divergence among different scarab pests6,7,8,30,31. Both H. oblita and H. parallela belong to Melolonthinae, with similar morphological features and ecological taxonomic status, but the different adaptation abilities against pathogens indicate that they might have different environment adaptation strategy. Through biological characteristic analysis of these two scarabs, we find that H. oblita can form a specific SEC structure surrounding the eggs which H. parallela cannot. And the young H. oblita larva completes the initial development process inside this structure, which provides a relatively stable microenvironment beneficial to the development of the eggs and the stability of egg surface bacteria community. In this paper, beta diversity analysis indicated that the community of SEC structure is affected by the eggs and its surface bacteria. Therefore, according to the antimicrobial activity of egg surface bacteria, we speculate that this SEC structure possesses less anti-pathogen bacteria and provides protection for the eggs and hatchlings of H. oblita.
Female insects can vertically transmit to their offspring many beneficial bacteria which help the young hatchling inhibiting microbial competitors and pathogens, through different mechanisms. For example, the Plataspidae females (Heteroptera) enable their hatchlings acquire their gut symbiont by depositing symbiont capsules on the underside of the egg mass32; dung beetles transmit the symbionts to their larvae vertically by maternal fecal secretions deposited in the dung balls together with eggs33. In the present work, 16S rRNA sequencing analysis indicated that H. oblita egg surface exhibited a unique microbial community feature with significantly lower microbial diversity and significantly higher community unevenness. Furthermore, 42.72% OTUs (N = 872) in egg surface cannot be detected in both bulk soil and SEC structure, indicating that the unique bacterial community might originate from maternal transmission. Community composition analysis indicated that these bacteria possessed potential antimicrobial activity against pathogens. At the genus level, the composition of Clostridium, Enterococcus, Pseudomonas, Acinetobacter, Desulfovibrio, Delftia, Sphingobium, Brevundimonas, Comamonas, Dysgonomonas, Emticicia, Empedobacter and Sebaldella significantly increased in egg surface (Table S6), some of which have also been reported to exhibit antimicrobial activity against various pathogens. For example, many species of genus Pseudomonas have been proved synthesize a variety of compounds with antagonistic activity28,34; species of Delftia and Sphingobium produce antimicrobial compounds, which inhibit the growth of some common pathogenic microbes35,36. The further confrontation culture analysis confirmed the antimicrobial activity of egg surface bacteria against Bt and Bb, and the secondary metabolite analysis demonstrated the potential biosynthesis ability of antimicrobial compounds in these anti-pathogen isolates. For example, phenazines were reported to have antibiotic properties toward many bacteria and fungi and can damage mammalian cells37,38; thiopeptide antibiotics are a prominent class of antimicrobials with potent activity against gram-positive bacteria and many drug-resistant pathogens39. Therefore, these egg surface bacteria could reduce the pathogen infection probability through inhibiting the multiplication of Bb and Bt. Additionally, egg surface bacteria may help the larvae build a beneficial intestinal microbiota. Under natural conditions, the newly hatched larvae have a great chance to contact and ingest these microorganisms on the egg surface and the nearby soil, and some species that can colonize in the intestine will form the intestinal microbiota. The previous study has demonstrated that scarab larvae gut isolates exhibit antimicrobial activity against Bt strains, including these species with predominance in egg surface, such as Acinetobacter40.
Summarizing, the egg surface has a unique and antimicrobial bacterial community, which might originate from maternal transmission, contributing to the adaptability of scarabs. And the specific SEC structure surrounding the H. oblita eggs will provide a stable microenvironment for the eggs and egg surface bacteria, which probably provide a better adaptation ability for H. oblita.
Methods
Sampling and DNA extraction
H. oblita was collected from a field in Cangzhou, Hebei Province, China. The adults were reared in plastic boxes (66 cm by 41 cm by 18 cm) filled with soil containing willow leaves at a temperature of 25 ℃ until they laid eggs. SEC (C) samples and egg surface (E) samples were collected as shown in the Fig. 1, and bulk soil (B) samples were collected from the soil about 10 cm away from the egg surface.
SECs were collected and peeled off, then the eggs were transferred to a sterile 2 ml plastic centrifuge tube containing 1 ml sterile water and sonicated for 5 min in an Bransonic CPX Ultrasonic Cleaning Bath (BRANSON, USA) to dislodge bacteria. After centrifugation at 10,000×g for 5 min, the microorganisms in the wash buffer were collected and defined as the egg surface (E) sample, and resuspended with 1 ml sterile water. The SEC soils (1 g) and soils (1 g) 10 cm away from the SECs were suspended in 5 ml sterile water and centrifuged at 10,000×g for 5 min, and the pellets were defined as the SEC (C) sample and the bulk soil (B) sample and resuspended with 1 ml sterile water. A total of 20 samples were collected, including 6 E samples, 7 C samples, and 7 B samples.
For egg surface (E) samples, 1 μl of the microorganism suspension was directly used as a template for PCR. For soil samples (B and C), a 900 μl suspension was used to extract genomic DNA, using a PowerSoil DNA Isolation kit (MO BIO Laboratories, USA), and 1 μl of DNA was used as a template for PCR amplification. The remaining 100 μl suspension of 20 samples was kept for conventional culture using solid Luria Bertani (LB) agar medium, and single colonies were picked from the plates and repeatedly grown on solid agar plates until pure cultures were obtained. A total of 28 cultivable isolates were collected, including 3 isolates from E samples, 7 isolates from C samples, and 18 isolates from B samples. Genomic DNA of each isolate was extracted as previously described41.
16S rRNA gene sequencing and bioinformatic analysis
The V3–V4 region of microbial 16S rRNA genes of 20 samples were amplified by PCR using the specific primers, 341F (5′-CCTAYGGGRBGCASCAG-3′) and 806R (5′-GGACTACNNGGGTATCTAAT-3′). PCR products were purified using a QIAquick Gel Extraction Kit (QIAGEN, Germany). The TruSeq DNA PCR-Free Sample Preparation Kit (ILLUMINA, USA) was used for 16S rRNA gene amplicon library construction. The Qubit 2.0 Fluorometer (Thermo Fisher SCIENTIFIC, USA) and Agilent 2100 Bioanalyzer (Agilent Technologies, USA) were used for library quality assessment. Finally, the library was sequenced on the Illumina HiSeq 2500 sequencer (ILLUMINA, USA), and 250 bp paired-end reads were generated. Raw Data were trimmed using Trimmomatic (version 0.36)42 with default parameters. Then the clean paired-end reads were assembled into raw tags using Usearch (version 9.2.64)43. The primer sequences in the raw tags were trimmed, and effective tags were obtained. The 16S rRNA sequence data of 20 samples were deposited in Sequence Read Archive (SRA) database under BioProject ID PRJNA637400, with accession number SRR11931252–SRR11931271.
The operational taxonomic units (OTUs) were clustered at 97% identity cutoff with a Usearch UPARSE algorithm44. Then the chimera sequences were removed based on the UPARSE pipeline analysis. The OTU annotation was performed using the Usearch SINTAX algorithm45, against RDP training set (version 16) 16S rRNA Database with a confidence threshold of 0.8. OTUs annotated as chloroplast or mitochondria or OTUs not annotated to the kingdom level were abandoned. QIIME (version 1.7.0) pyNAST algorithm46 was used for species annotation against the GreenGene Database47. Usearch (version 9.2.64)43 was used to calculate Alpha diversity metrics, including the indexes (Shannon, Chao1) reflecting the sample community richness, and indexes (Simpson, Dominance, and Equitability) reflecting the sample community evenness. QIIME (version 1.7.0)48 was used to calculate beta diversity to estimate variation between samples. Principal Component Analysis (PCA) and Non-Metric Multi-Dimensional Scaling (NMDS) analysis were performed using R package (https://www.r-project.org/) to visualize complex relationships between samples. Lda Effective Size (LEfSe) test for variability of microbiota was calculated using lefse (Version 1.0.7) (http://huttenhower.sph.harvard.edu/galaxy/).
For 28 cultivable isolates, the 16S rRNA genes of each isolate were amplified using the specific primers, 27F (5′-AGAGTTTGATCMTGGCTCAG-3′) and 1492R (5′-TACCTTGTTACGACTT-3′). Then the 16S rRNA sequences were identified through aligning against NCBI 16S rRNA sequence (Bacteria and Archaea) database with BLAST (https://blast.ncbi.nlm.nih.gov/Blast.cgi).
Confrontation culture analysis
Four entomopathogen strains were used: 3 scarab-specific Bt strains (HBF-1, HBF-18, Bt185) 6,49,50, and one Bb strain BBNS-J9-16 (preservation number: CGMCC No.5288). The dual culture tests for antagonistic ability of 28 cultivable isolates against Bt strains were processed using the cup-plate confrontation culture method, as previously described40. Sterile water was used as a negative control. The observable inhibition zones were used as indicators of the antibacterial activity of the 28 isolates against Bt strains.
For the antagonistic ability analysis of the 28 isolates against Bb strain, the isolates were cultured at 30 ℃ with shaking at 220 rpm. The Bb strain was cultured on PDA for 2–4 days. Subsequently, fungal culture plugs were placed in the middle of LB agar plates. Five dishes of sterile blotter paper (6 mm diam.) were placed on the surface of the plate and inoculated with 10 μl of the cultured bacterial suspension. The amphotericin-B and sterile water were used as positive and negative controls, respectively. The plates were incubated at 28 ℃ for 5 days, and inhibition zones induced by 28 isolates against Bb strain were recorded.
Genome sequencing and secondary metabolite analysis
Four cultivable isolates with strong antagonistic ability against Bt strains and weak antagonistic ability against Bb strain were selected for draft genome sequencing, using the Illumina HiSeq 2500 sequencer (ILLUMINA, USA). The produced reads were cleaned by removing reads with Ns or more than 20% low-quality bases, and 1 Gb 2 × 100 bp pair-end clean reads for each isolate were obtained. The Megahit (v 1.2.9)51 was used for genome assembly with default parameter, and QUAST (v 5.0.2)52 was used for quality assessment for genome assembly. In addition, the Prodigal (v 2.6.3)53 was performed for gene prediction. And the antiSMASH 2.0 pipeline54 was used for secondary metabolite analysis of these four isolates. The genome sequence data of four isolates were deposited in NCBI database under BioProject ID PRJNA715633, with accession number JAGFLW000000000, JAGFLX000000000, JAGFLV000000000, and JAGFLU000000000.
Phylogenetic analysis
All the 16S rRNA sequences of 28 cultivable isolates were analyzed using MEGA (version 7)55 and an online tool iTOL: Interactive Tree of Life (http://itol.embl.de/)56. The analysis included bootstrapping values with 1000 replications. For the phylogenetic analysis of four genome sequenced isolates, we constructed the whole-genome-based tree using CVTree22 with k-string = 6, and PHYLIP57. The iTOL56 was used to annotate the tree.
References
Chen, H., Lin, L., Xie, M., Zhang, G. & Su, W. Influence of constant temperature on reproductive parameters of Holotrichia oblita (Coleoptera: Scarabaeidae). J. Insect Sci. 15, 93 (2015).
Gentil, C., Fantke, P., Mottes, C. & Basset-Mens, C. Challenges and ways forward in pesticide emission and toxicity characterization modeling for tropical conditions. Int. J. Life Cycle Assess. 25, 1290–1306 (2019).
van Lenteren, J. C., Bolckmans, K., Köhl, J., Ravensberg, W. J. & Urbaneja, A. Biological control using invertebrates and microorganisms: Plenty of new opportunities. Biocontrol 64, 39–59 (2018).
Shu, C. et al. Characterization of two novel cry8 genes from Bacillus thuringiensis strain BT185. Curr. Microbiol. 58, 389–392 (2009).
Li, H. et al. Characterization of one novel cry8 gene from Bacillus thuringiensis strain Q52–7. World J. Microbiol. Biotechnol. 30, 3075–3080 (2014).
Shu, C. et al. Characterization of a novel cry8 gene specific to Melolonthidae pests: Holotrichia oblita and Holotrichia parallela. Appl. Microbiol. Biotechnol. 84, 701–707 (2009).
Nong, X. et al. Laboratory evaluation of entomopathogenic fungi against the white grubs, Holotrichia oblita and Anomala corpulenta (Coleoptera: Scarabaeidae) from the field of peanut, Arachis hypogaea. Biocontrol Sci. Technol. 21, 593–603 (2011).
Bi, Y. et al. Genomic sequencing identifies novel Bacillus thuringiensis Vip1/Vip2 binary and Cry8 toxins that have high toxicity to Scarabaeoidea larvae. Appl. Microbiol. Biotechnol. 99, 753–760 (2015).
Li, G., Feng, H., Ji, T., Huang, J. & Tian, C. What type of Bt corn is suitable for a region with diverse lepidopteran pests: A laboratory evaluation. GM Crops Food 12, 115–124 (2021).
Zimmermann, G. Review on safety of the entomopathogenic fungi Beauveria bassiana and Beauveria brongniartii. Biocontrol Sci. Technol. 17, 553–596 (2007).
Soberón, M., Gill, S. S. & Bravo, A. Signaling versus punching hole: How do Bacillus thuringiensis toxins kill insect midgut cells?. Cell. Mol. Life Sci. 66, 1337–1349 (2009).
Raymond, B., Johnston, P. R., Nielsen-LeRoux, C., Lereclus, D. & Crickmore, N. Bacillus thuringiensis: An impotent pathogen?. Trends Microbiol. 18, 189–194 (2010).
Garbutt, J., Bonsall, M. B., Wright, D. J. & Raymond, B. Antagonistic competition moderates virulence in Bacillus thuringiensis. Ecol. Lett. 14, 765–772 (2011).
Raymond, B., Wyres, K. L., Sheppard, S. K., Ellis, R. J. & Bonsall, M. B. Environmental factors determining the epidemiology and population genetic structure of the Bacillus cereus group in the field. PLoS Pathog. 6, e1000905 (2010).
Laznik, Ž & Trdan, S. Failure of entomopathogens to control white grubs (Coleoptera: Scarabaeidae). Acta Agric. Scand. B Soil Plant Sci. 65, 95–108 (2015).
Esteves, E. et al. Antimicrobial activity in the tick Rhipicephalus (Boophilus) microplus eggs: Cellular localization and temporal expression of microplusin during oogenesis and embryogenesis. Dev. Comp. Immunol. 33, 913–919 (2009).
Yu, Z. et al. Antimicrobial activity in the egg wax of the tick Amblyomma hebraeum (Acari: Ixodidae) is associated with free fatty acids C16:1 and C18:2. Exp. Appl. Acarol. 58, 453–470 (2012).
Babczyńska, A. et al. Sterile capsule-egg cocoon covering constitutes an antibacterial barrier for spider Parasteatoda tepidariorum embryos. Physiol. Biochem. Zool. 92, 115–124 (2019).
Tian, X. et al. Template preparation affects 16S rRNA high-throughput sequencing analysis of phyllosphere microbial communities. Front. Plant Sci. 8, 1623 (2017).
Spain, A. M., Krumholz, L. R. & Elshahed, M. S. Abundance, composition, diversity and novelty of soil Proteobacteria. ISME J. 3, 992–1000 (2009).
Mendes, L. W., Kuramae, E. E., Navarrete, A. A., Van Veen, J. A. & Tsai, S. M. Taxonomical and functional microbial community selection in soybean rhizosphere. ISME J. 8, 1577–1587 (2014).
Qi, J., Wang, B. & Hao, B. Whole proteome prokaryote phylogeny without sequence alignment: A K-string composition approach. J. Mol. Evol. 58, 1–11 (2004).
Wang, H., Xu, Z., Gao, L. & Hao, B. A fungal phylogeny based on 82 complete genomes using the composition vector method. BMC Evol. Biol. 9, 195 (2009).
Zuo, G., Xu, Z. & Hao, B. Phylogeny and taxonomy of Archaea: A comparison of the whole-genome-based CVTree approach with 16S rRNA sequence analysis. Life (Basel, Switzerland) 5, 949–968 (2015).
Lister, P. D., Wolter, D. J. & Hanson, N. D. Antibacterial-resistant Pseudomonas aeruginosa: Clinical impact and complex regulation of chromosomally encoded resistance mechanisms. Clin. Microbiol. Rev. 22, 582–610 (2009).
Ali, N. I., Siddiqui, I. A., Shaukat, S. S. & Zaki, M. J. Nematicidal activity of some strains of Pseudomonas spp. Soil Biol. Biochem. 34, 1051–1058 (2002).
Wahla, V., Maheshwari, D. K. & Bajpai, V. K. Nematicidal fluorescent pseudomonads for the in vitro and in vivo suppression of root knot (Meloidogyne incognita) of Capsicum annuum L. Pest Manag. Sci. 68, 1148–1155 (2012).
Nga, N. et al. Control of plant diseases by the endophytic rhizobacterial strain Pseudomonas aeruginosa 231-1. Recent Advances in Biofertilizers and Biofungicides for Sustainable Agriculture. Asian Conference on Plant Growth-Promoting Rhizobacteria and Other Microbials, Chapter 2, 14–37 (2013).
Smith, D. M. & Marcot, J. D. The fossil record and macroevolutionary history of the beetles. Proc. R. Soc. B 282, 20150060 (2015).
Zhang, Y., Zheng, G., Tan, J., Li, C. & Cheng, L. Cloning and characterization of a novel cry8Ab1 gene from Bacillus thuringiensis strain B-JJX with specific toxicity to scarabaeid (Coleoptera: Scarabaeidae) larvae. Microbiol. Res. 168, 512–517 (2013).
Shu, C. et al. Characterization of two novel Bacillus thuringiensis Cry8 toxins reveal differential specificity of protoxins or activated toxins against Chrysomeloidea Coleopteran superfamily. Toxins 12, 642 (2020).
Fukatsu, T. & Hosokawa, T. Capsule-transmitted gut symbiotic bacterium of the Japanese common plataspid stinkbug, Megacopta punctatissima. Appl. Environ. Microbiol. 68, 389–396 (2002).
Shukla, S. P., Sanders, J. G., Byrne, M. J. & Pierce, N. E. Gut microbiota of dung beetles correspond to dietary specializations of adults and larvae. Mol. Ecol. 25, 6092–6106 (2016).
Vachée, A., Mossel, D. A. & Leclerc, H. Antimicrobial activity among Pseudomonas and related strains of mineral water origin. J. Appl. Microbiol. 83, 652–658 (1997).
Nguyen, T. M. & Kim, J. Sphingobiumaromaticivastans sp. nov., a novel aniline- and benzene-degrading, and antimicrobial compound producing bacterium. Arch. Microbiol. 201, 155–161 (2019).
Tejman-Yarden, N. et al. Delftibactin-A, a non-ribosomal peptide with broad antimicrobial activity. Front. Microbiol. 10, 2377 (2019).
Norman, R. S., Moeller, P., McDonald, T. J. & Morris, P. J. Effect of pyocyanin on a crude-oil-degrading microbial community. Appl. Environ. Microbiol. 70, 4004–4011 (2004).
Gibson, J., Sood, A. & Hogan, D. A. Pseudomonas aeruginosa-candida albicans interactions: Localization and fungal toxicity of a phenazine derivative. Appl. Environ. Microbiol. 75, 504–513 (2009).
Bagley, M. C., Dale, J. W., Merritt, E. A. & Xiong, X. Thiopeptide antibiotics. Chem. Rev. 105, 685–714 (2005).
Shan, Y., Shu, C., Crickmore, N., Liu, C. & Xiang, W. Cultivable gut bacteria of scarabs (Coleoptera: Scarabaeidae) inhibit Bacillus thuringiensis multiplication. Environ. Entomol. 43, 612–616 (2014).
Shu, C. et al. Characterization of cry9Da4, cry9Eb2, and cry9Ee1 genes from Bacillus thuringiensis strain T03B001. Appl. Microbiol. Biotechnol. 97, 9705–9713 (2013).
Bolger, A. M., Lohse, M. & Usadel, B. Trimmomatic: A flexible trimmer for Illumina sequence data. Bioinformatics 30, 2114–2120 (2014).
Alloui, T., Boussebough, I., Chaoui, A., Nouar, A. Z. & Chettah, M. C. Usearch: A meta search engine based on a new result merging strategy. Int. Joint Conf. Knowl. Discov. 1, 531–536 (2015).
Edgar, R. C. UPARSE: Highly accurate OTU sequences from microbial amplicon reads. Nat. Methods 10, 996–998 (2013).
Edgar, R. C. SINTAX: A simple non-Bayesian taxonomy classifier for 16S and ITS sequences. bioRxiv, 074161 (2016).
Caporaso, J. G. et al. PyNAST: A flexible tool for aligning sequences to a template alignment. Bioinformatics 26, 266–267 (2010).
DeSantis, T. Z. et al. Greengenes, a chimera-checked 16S rRNA gene database and workbench compatible with ARB. Appl. Environ. Microbiol. 72, 5069–5072 (2006).
Caporaso, J. G. et al. QIIME allows analysis of high-throughput community sequencing data. Nat. Methods 7, 335–336 (2010).
Shu, C. et al. Improving toxicity of Bacillus thuringiensis strain contains the cry8Ca gene specific to Anomala corpulenta larvae. Curr. Microbiol. 55, 492–496 (2007).
Yu, H., Zhang, J., Huang, D., Gao, J. & Song, F. Characterization of Bacillus thuringiensis strain Bt185 toxic to the Asian cockchafer: Holotrichia parallela. Curr. Microbiol. 53, 13–17 (2006).
Li, D., Liu, C., Luo, R., Sadakane, K. & Lam, T. MEGAHIT: An ultra-fast single-node solution for large and complex metagenomics assembly via succinct de Bruijn graph. Bioinformatics 31, 1674–1676 (2015).
Gurevich, A., Saveliev, V., Vyahhi, N. & Tesler, G. QUAST: Quality assessment tool for genome assemblies. Bioinformatics 29, 1072–1075 (2013).
Hyatt, D. et al. Prodigal: Prokaryotic gene recognition and translation initiation site identification. BMC Bioinform. 11, 119 (2010).
Medema, M. H. et al. antiSMASH: Rapid identification, annotation and analysis of secondary metabolite biosynthesis gene clusters in bacterial and fungal genome sequences. Nucleic Acids Res. 39, 339–346 (2011).
Kumar, S., Stecher, G. & Tamura, K. MEGA7: Molecular evolutionary genetics analysis version 7.0 for bigger datasets. Mol. Biol. Evol. 33, 1870–1874 (2016).
Letunic, I. & Bork, P. Interactive tree of life (iTOL) v3: An online tool for the display and annotation of phylogenetic and other trees. Nucleic Acids Res. 44, 242–245 (2016).
Felsenstein, J. PHYLIP-phylogeny inference package (Version 3.2). Cladistics Int. J. Willi Hennig Soc. 5, 164–166 (1989).
Acknowledgements
This research was funded by the National Key Research and Development Program of China (Grant: 2017YFD0201200), and the National Natural Science Foundation of China (No. 32070511).
Author information
Authors and Affiliations
Contributions
C.S., G.W. and J.Z. designed the study, C.L. and L.G. provided the insect and collected samples, Q.L. carried out the experimental work, K.W. did the data analysis, K.W. and C.S. wrote the manuscript. All authors read and approved the final version of the manuscript.
Corresponding author
Ethics declarations
Competing interests
The authors declare no competing interests.
Additional information
Publisher's note
Springer Nature remains neutral with regard to jurisdictional claims in published maps and institutional affiliations.
Supplementary Information
Rights and permissions
Open Access This article is licensed under a Creative Commons Attribution 4.0 International License, which permits use, sharing, adaptation, distribution and reproduction in any medium or format, as long as you give appropriate credit to the original author(s) and the source, provide a link to the Creative Commons licence, and indicate if changes were made. The images or other third party material in this article are included in the article's Creative Commons licence, unless indicated otherwise in a credit line to the material. If material is not included in the article's Creative Commons licence and your intended use is not permitted by statutory regulation or exceeds the permitted use, you will need to obtain permission directly from the copyright holder. To view a copy of this licence, visit http://creativecommons.org/licenses/by/4.0/.
About this article
Cite this article
Wang, K., Liu, Q., Liu, C. et al. Dominant egg surface bacteria of Holotrichia oblita (Coleoptera: Scarabaeidae) inhibit the multiplication of Bacillus thuringiensis and Beauveria bassiana. Sci Rep 11, 9499 (2021). https://doi.org/10.1038/s41598-021-89009-6
Received:
Accepted:
Published:
Version of record:
DOI: https://doi.org/10.1038/s41598-021-89009-6
This article is cited by
-
Coconut rhinoceros beetle digestive symbiosis with potential plant cell wall degrading microbes
npj Biofilms and Microbiomes (2024)